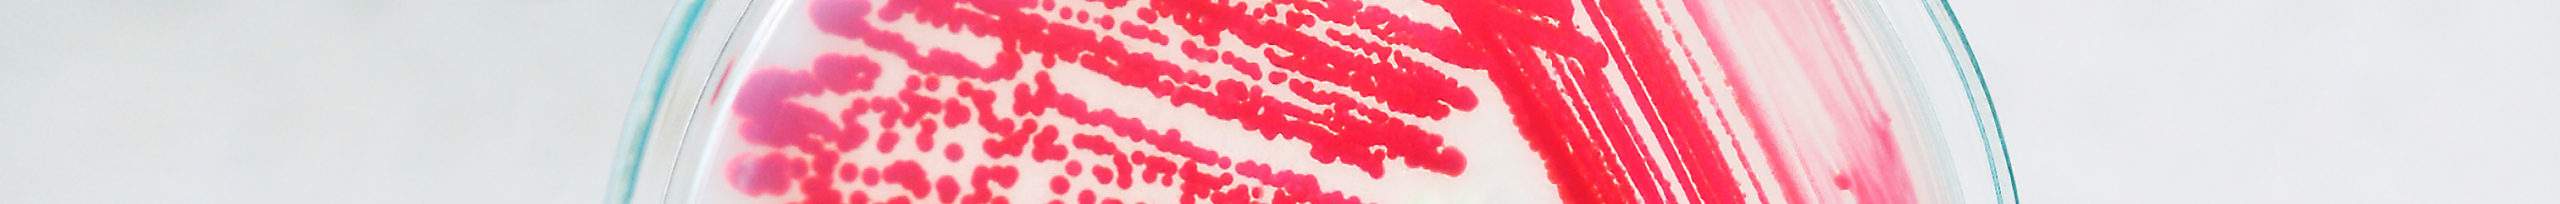

Microbiology
The microbiology program includes a wide spectrum of reagents, tests and consumables used in the clinical microbiology laboratories, microbiology laboratories in the pharmaceutical and food industry, as well as health ecologies laboratories.
The manufacturing program includes:
– additives to animal blood agar base – BioSap additives for blood medium production
– BioSap SO – defibrinated and reoxygenated sheep blood base additive
– BioSap HO – defibrinated and reoxygenated horse blood base additive
– BioSap HCO – reoxygenated horse blood base additive with sodium citrate
– BioSap HL – lysed horse blood base additive
Among additives used for microbiology growth medium production are other reagents for serological diagnostics like sheep and horse erythrocytes suspensions in Alsever’s solution and erythrocyte concentrates
– rapid tests for infectious diseases (bacterial and viral antigen detection, and detection of parasites and toxins)
The distributive program includes:
– dehydrated growth medium bases (powdered, chromogenic, granulated) and supplements, antibiotic discs
– identification tests and discs, latex kits
– rapid tests for detection of M. tuberculosis complexes, bacteria and their toxins
– control strains for quality control in microbiology laboratories
– controls for molecular diagnostics
– Real-time PCR kits (open instrument platform) and manual nucleic acid isolation (RNA/DNA)
COVID-19 diagnostics:
– rapid immunochromatographic assays for detection of IgM and IgG specific for SARS-CoV-2
– Real-time PCR kits for SARS-CoV-2
– manual RNA/DNA isolation kit
– SARS-CoV-2 molecular controls
– consumables for PCR diagnostics
Gastroenterology assays:
– rapid urease assay for detection of H.pylori from the gastric mucosa biopsy
– rapid immunochromatographic assay for detection of the fecal calprotectin
– rapid assay for detection of H.pylori from the stool, serum, plasma and whole blood sample
– rapid assay for detection of H.pylori and transferrin from a stool sample
– rapid fecal occult blood test (chemical and immunochemical)
No products were found matching your selection.